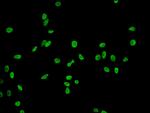
H2BK20ac (type 1-B) Antibody in Immunocytochemistry (ICC/IF)

Search
Invitrogen
Acetyl-HIST1H2BB (Lys20) Recombinant Rabbit Monoclonal Antibody (21F11)
{{$productOrderCtrl.translations['antibody.pdp.commerceCard.promotion.promotions']}}
{{$productOrderCtrl.translations['antibody.pdp.commerceCard.promotion.viewpromo']}}
{{$productOrderCtrl.translations['antibody.pdp.commerceCard.promotion.promocode']}}: {{promo.promoCode}} {{promo.promoTitle}} {{promo.promoDescription}}. {{$productOrderCtrl.translations['antibody.pdp.commerceCard.promotion.learnmore']}}
图: 1 / 4
Acetyl-HIST1H2BB (Lys20) Antibody (MA5-33154) in ICC/IF

产品信息
MA5-33154
种属反应
宿主/亚型
Expression System
分类
类型
克隆号
抗原
偶联物
形式
浓度
规格
纯化类型
保存液
内含物
保存条件
运输条件
RRID
靶标信息
Core component of nucleosome. Nucleosomes wrap and compact DNA into chromatin, limiting DNA accessibility to the cellular machineries which require DNA as a template. Histones thereby play a central role in transcription regulation, DNA repair, DNA replication and chromosomal stability. DNA accessibility is regulated via a complex set of post-translational modifications of histones, also called histone code, and nucleosome remodeling.
仅用于科研。不用于诊断过程。未经明确授权不得转售。
篇参考文献 (0)
生物信息学
蛋白别名: H2B histone family, member F; H2B-clustered histone 3; H2B/f; H2BFF; HIST1H2BB; histone 1, H2bb; histone cluster 1 H2B family member b; histone cluster 1, H2bb; Histone H2B type 1-B; Histone H2B.1; Histone H2B.f
基因别名: H2B.1; H2B/f; H2BC3; H2BFF; HIST1H2BB
UniProt ID: (Human) P33778
Entrez Gene ID: (Human) 3018



